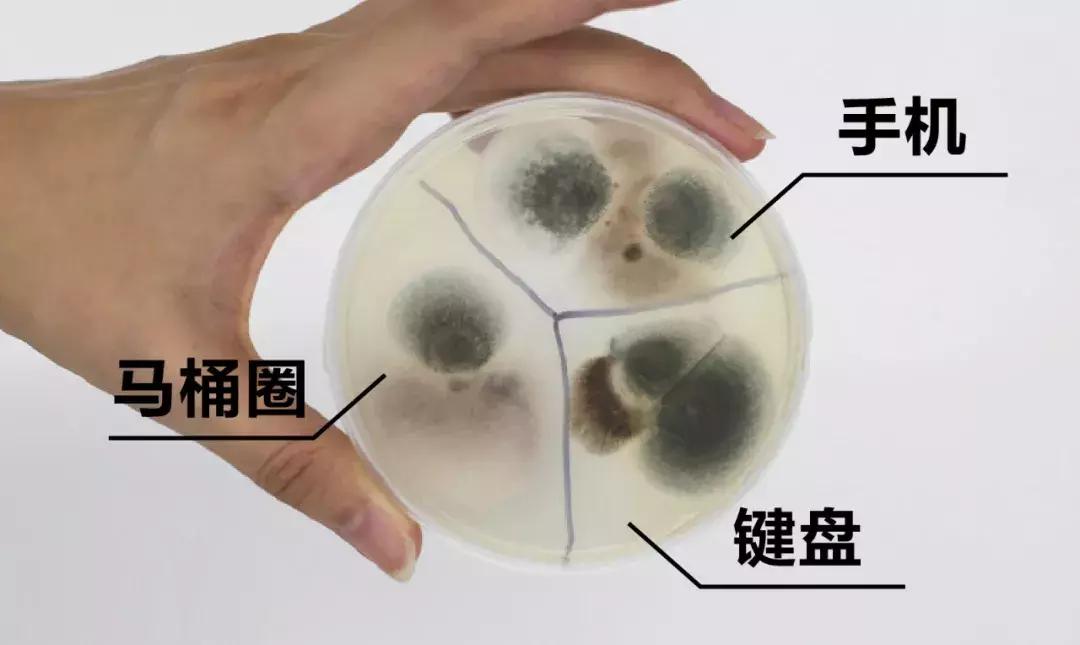
清洁软胶帮你清洁家里每个角落,清洁软胶如何把上面的污垢搞掉

我们每天要对着电脑工作
键盘是你必须接触的东西
你在奋力工作的时候
键盘却在悄悄危害着你

而且有时候为了节省时间
就在电脑前解决午餐了
键盘缝隙里面经常会充满各种奇怪的东西

咦额~真的太恶心了~
美国亚利桑那大学的研究显示
每平方英寸的键盘藏有3295种细菌
相比之下卫生间的马桶座圈
每平方英寸才有49种细菌
键盘细菌比马桶高了400多倍
细菌培养测试结果键盘细菌远高于马桶圈
而你却用刚打完字的手
拿起旁边的食物一口塞进嘴里
无数的细菌随之入口
想想都可怕
(或许你现在正在做这样的事儿)

不仅如此
你平时使用的
手机、数码相机、耳机、化妆品、车内饰
甚至您孩子的玩具等
都有着超出你想象的细菌数量



千万不要小瞧这些细菌
链球菌、绿脓杆菌
芽孢杆菌、沙眼依原体等
都是造成皮肤病、眼病
和胃肠道等疾病的重要原因
2002年曾在某大学爆发的红眼流行病
后来研究表明
公用计算机键盘是使部分学生
患上红眼病的主要感染源

可是键盘里面不好清理啊
数码产品、车内饰也清理不到缝隙
看着缝隙里的污垢就心烦
有没有简单方便
不需要用水清洗
还能除污杀菌的方法呢?
这不,长颈鹿又来推荐生活神器了
就是这款软么么清洁软胶了

BOOMER有料软么么清洁软胶(买多件更享优惠)小程序
这款堪称“死角垃圾杀手”的清洁神器
还一度登上在众多卫视节目
作为健康生活必备推荐
东方卫视的《就是爱漂亮》
▼

旅游卫视的《美丽俏佳人》
▼

湖南卫视的《我是大美人》
▼

软么么经历了5年的市场验证
得到了众多粉丝的拥护

如今第二代换了全新的包装
产品性能也更加的升级

软么么的质地非常柔软
呈乳白色半透明状
拿在手上有点清凉
可以随意拉扯揉捏
也不会沾到手上

正是它因为有着极强的延展性
任何细小的缝隙它都能钻进去
1分 钟就可以粘出
你藏了10年的缝隙垃圾

有疯狂的粉丝进行了一次实验
毁灭性的将垃圾倒到键盘上
但是用软么么轻松的就清理干净了


除了可以清理键盘外
您身边的几乎所有物品都能清理
无所不能,无孔不入

比如你的爱车也有着众多难以打理的位置
空调出风口、饮料槽、方向盘按键等等
都可以轻松清洁

还有你心爱的古玩艺术品
复杂的造型很难细致清理
但软么么可以深入隙缝

再比如你的包包
很多皮质包包有着复杂的纹路
用它可以轻松除灰,提亮质感

甚至还有你的花花草草
也可以用软么么清洁杀菌

那么大家会问,这样一片能用多久呢?
总不会是一次性的吧?
当然不会,经实测可以使用20次左右
当胶体逐渐变灰褐色
就说明使用寿命已经到了

而这样折算下来
每次清洁都还不到5毛钱
可以说非常划算了
现在购买6片和9片装还能更享优惠

BOOMER有料软么么清洁软胶(买多件更享优惠)小程序
软么么有这么强的吸附力
这得益于它不惜成本的使用
瑞士进口的高分子聚合物

这种材料有着高弹形变和高黏弹性
可轻易深入凹凸不平物品表面
或者狭窄缝隙等难以触及地方
而且绿色环保,无毒无害
放置空气中还可自然降解


除了可以有效吸附垃圾
软么么中的甲基异噻唑啉酮
还有着杀菌抑菌功能
小知识:甲基异噻唑啉酮(MIT)是一种高效杀菌剂,耐热之水性防腐剂,对于抑制微生物的生长有很好的作用,可以抑制细菌、真菌、霉菌及霉菌的生长。
为此研究人员做了一个测试
将细菌培养皿一分为二
右侧用软么么做了清洁
分别用1、2、3、9天进行了细菌监测
右侧的抑菌效果非常显著

由于它材料的可降解性
所以千万不要长期晾在空气中
软么么配备了自封袋
每次使用后建议及时放入袋中

它的包装也十分小巧
仅有一个iphone7大小
可以非常方便的放入口袋中

最后提醒一下大家
这款产品一经推出后
便涌进无数模仿者
但是由于原料不过关
导致很多客户买到各种不良品

比如我朋友买的这款比胶水还黏
根本无法使用
粘到键盘上就无法取下
最后只能直接把键盘丢了


而软么么拥有先进的厂房和设备
坚持进口原料
层层检测、质量保证
完全可以放心使用

使用注意事项
1、使用前建议拿出揉捏一下在使用;
2、不可水洗,使用后直接放入袋内即可;
3、使用前建议清洗双手,避免二次污染;
4、使用时按压清洁物,稍作停留后拉起即可;
5、避免和衣服放在一处;
6、置于阴凉处,避免暴晒,注意不可食用!
以前帮姑娘修电脑,自从给办公室姑娘们用了软么么清理键盘,每天见面么么哒!
